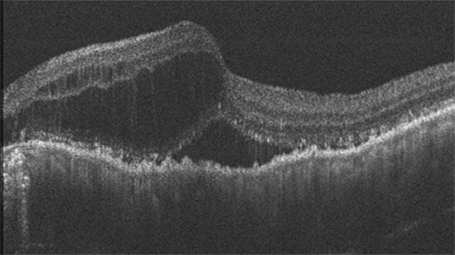

サービス概要
メディカルR&D
Home selfie OCTによる加齢黄斑変性のホームモニタリングシステム(特許第7082730号)
当社では、眼科で使われている検査機器「OCT(光干渉断層計)」と、最新のICT技術を組み合わせ、自宅で目の健康状態を確認できる「Home selfie OCT」を開発しました。
OCTは、目の奥の状態を細かく画像で捉えることができる機器で、当社の代表も開発に関わってきました。眼科の現場では、加齢黄斑変性や緑内障など、視力に大きく影響する病気の診断や治療に欠かせない機器です。
私たちの体は、血圧や血糖値のように、定期的に測ることで病気の早期発見や治療効果の確認がしやすくなります。目の病気も同様で、特に加齢黄斑変性や糖尿病黄斑浮腫といった病気では、病院での検査だけでなく、自宅でのこまめなチェックがとても重要です。
このような考えのもと、私たちはOCTにICTやAIなどのデジタル技術を融合し、日常生活の中で自然に目の健康を見守る新しい仕組みをつくっています。これにより、一人ひとりの健康管理に役立つとともに、医療の質や価値をさらに高めていきたいと考えています。